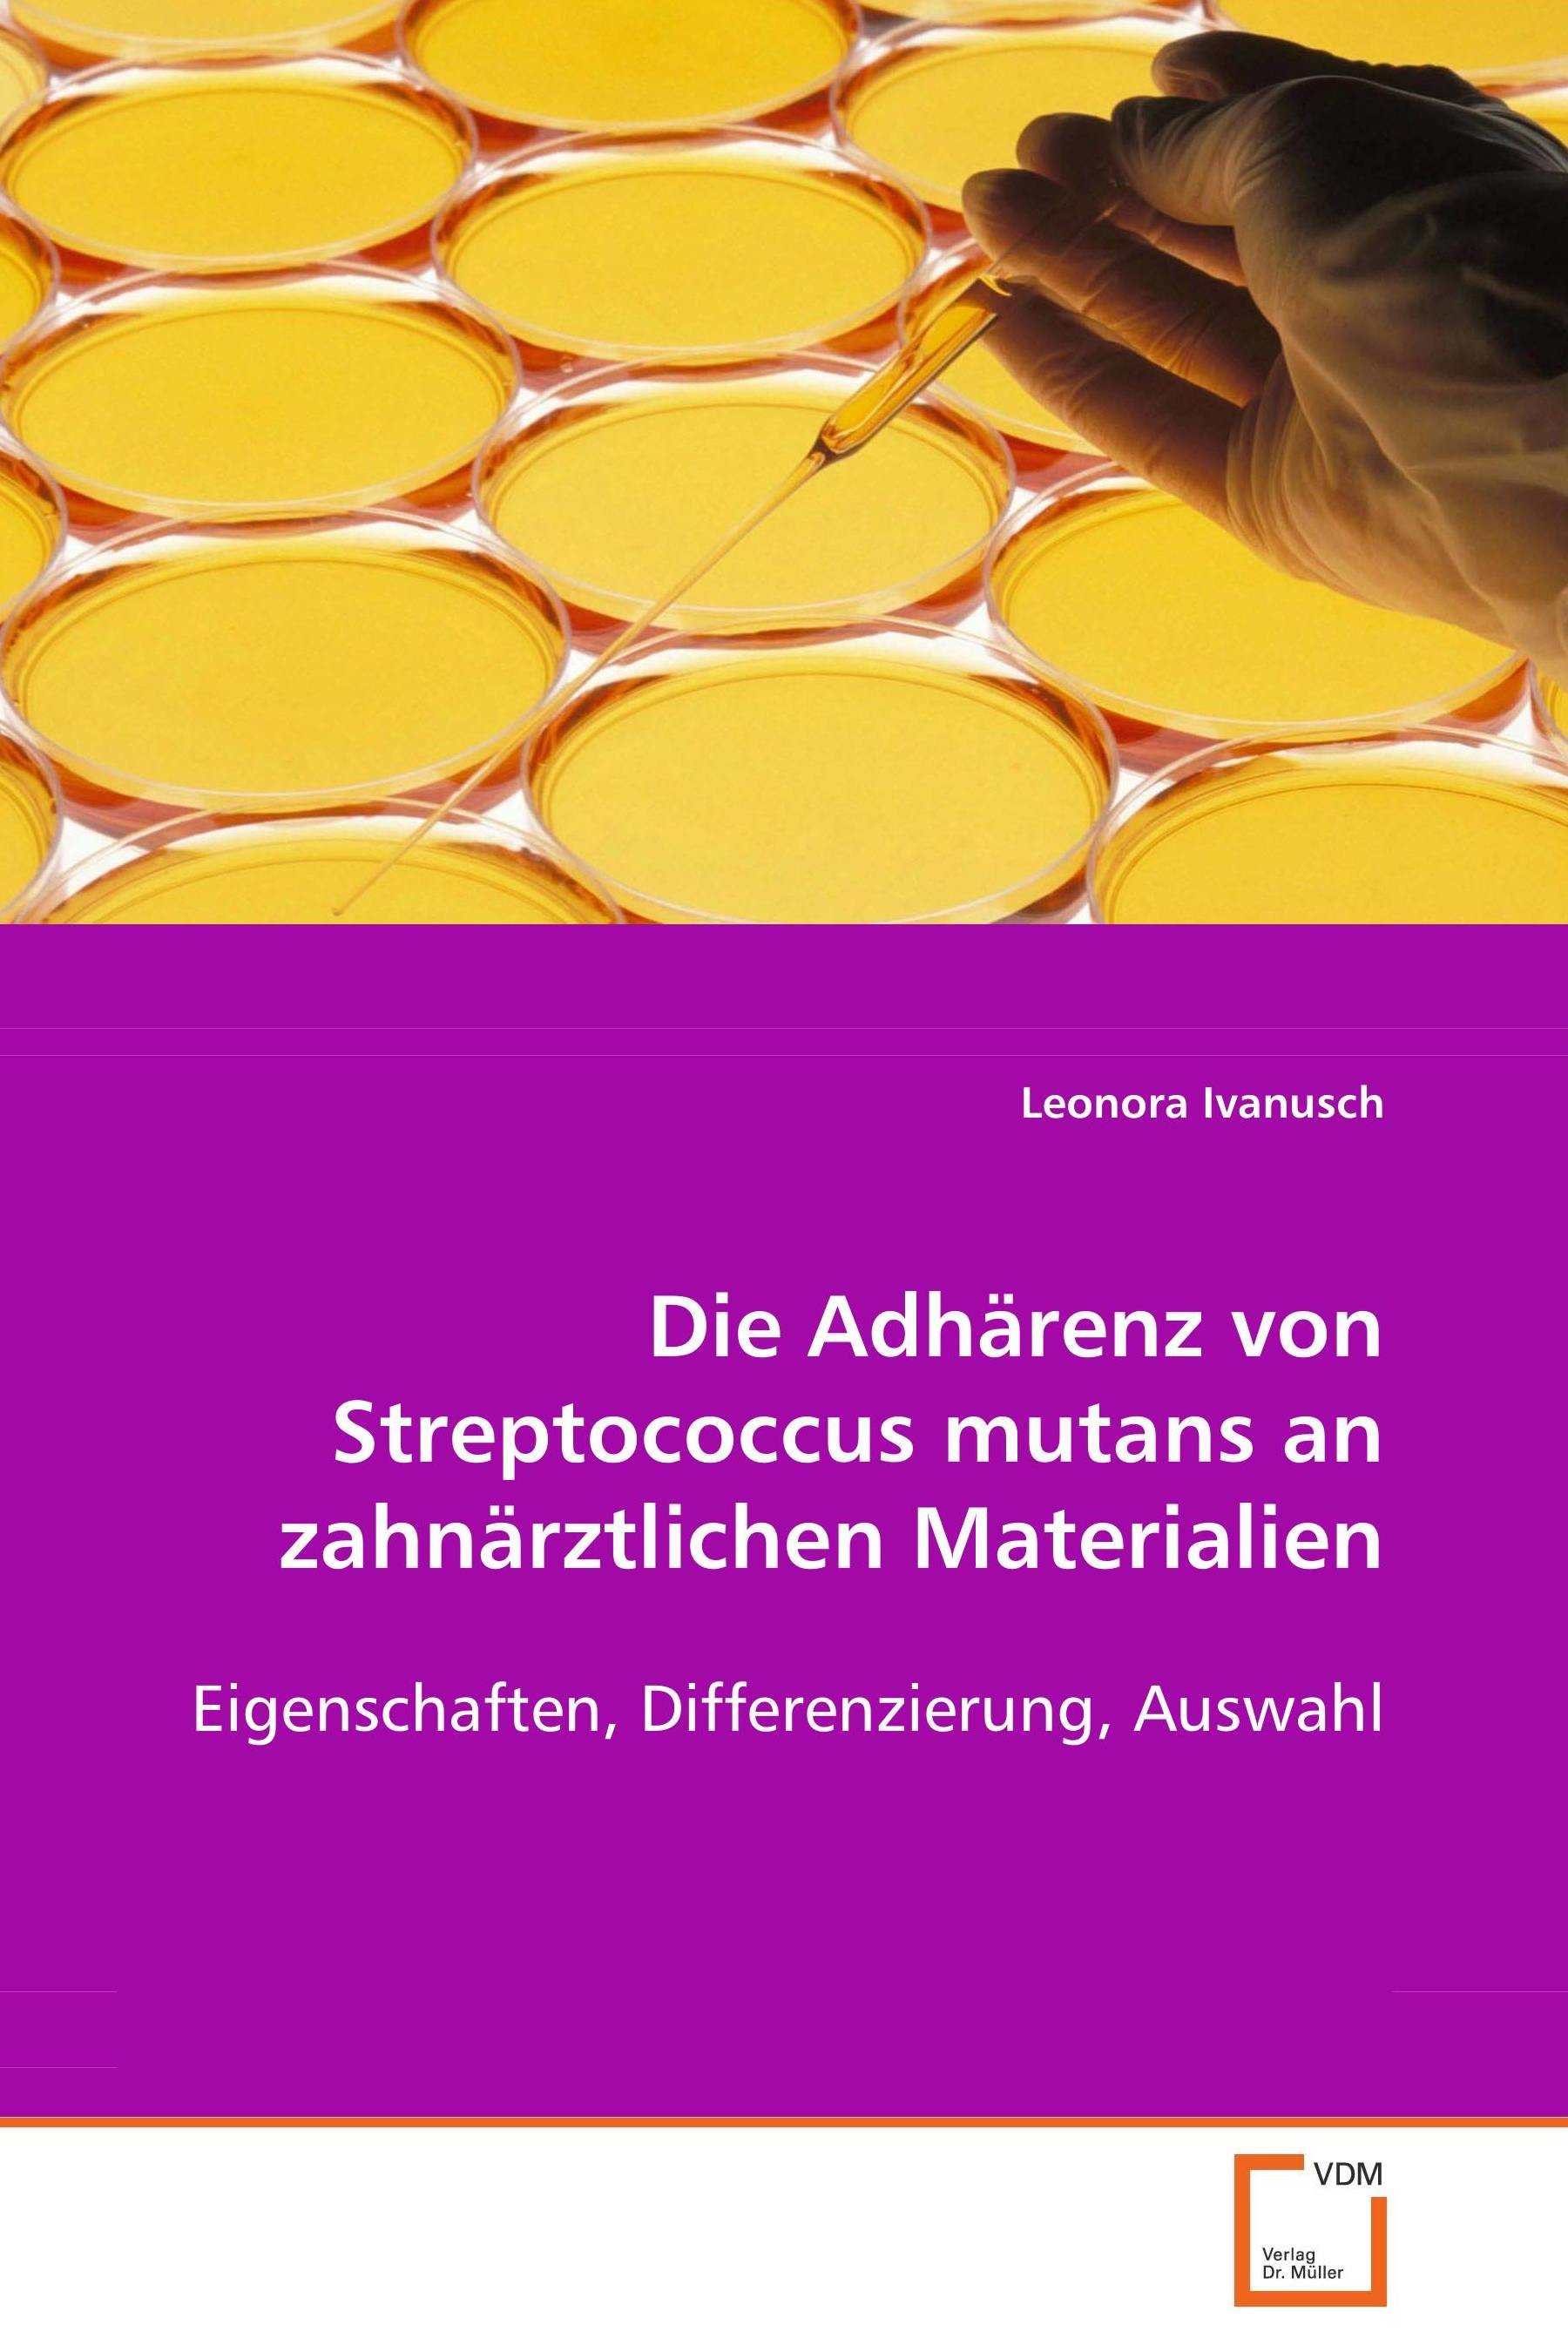
Die Adhärenz von Streptococcus mutans anzahnärztlichen Materialien

Die Adhärenz von Streptococcus mutans anzahnärztlichen Materialien
Eigenschaften , Differenzierung , Auswahl
| Auflage | 1. Auflage, 2008 |
| Verlag | VDM Verlag Dr. Mueller e.K. |
| ISBN | 9783639083934 |
Sofort zum Download (Download: PDF)
Produktbeschreibung
Bei der Entstehung von Zahnkaries spielt der in der Mundflora vorkommende Keim Streptococcus mutans die Hauptrolle. In diesem Buch wird dessen Adhärenz an 8 restaurativen Zahnersatzmaterialien erforscht, wobei ein Vergleich zu menschlichem Zahnschmelz und der Einfluss von Mundspeichel aufgezeigt wird. Die Ergebnisse und Prognosen dieser Forschung verhelfen zur präventiven, individuellen Auswahl von restaurativen Zahnersatzmaterialien in der Praxis. Aufnahmen mit dem Rasterelektronenmikroskop (REM) und deren Auswertung ergeben signifikant quantitative Unterschiede hinsichtlich der Keimbesiedelungsdichte auf den verschiedenen restaurativen Zahnersatzmaterialien. Der Zusammenhang zwischen der Keimbesiedelungsdichte, der Oberflächengegebenheit und der Materialbeschaffenheit werden detailliert dargestellt. Die resultierenden Ergebnisse basieren auf insgesamt 36.500 Stichproben. Das Buch richtet sich an Universitäten Fachrichtung Zahnmedizin/Mikrobiologie, Hochschulen, Wissenschaftler mit Schwerpunkt 'orale Mikrobiologie' sowie fachübergreifender Disziplinen, Fach- und Zahnärzte sowie Doktoranden.
Studium der Human- und Zahnmedizin / Multidisziplinäres Studium der Materialwissenschaften / Promotion an der Ruprecht-Karls-Universität Heidelberg / Fachhochschullehrerin Schwerpunkt 'orale Mikrobiologie' / Praktizierende Zahnärztin
Studium der Human- und Zahnmedizin / Multidisziplinäres Studium der Materialwissenschaften / Promotion an der Ruprecht-Karls-Universität Heidelberg / Fachhochschullehrerin Schwerpunkt 'orale Mikrobiologie' / Praktizierende Zahnärztin